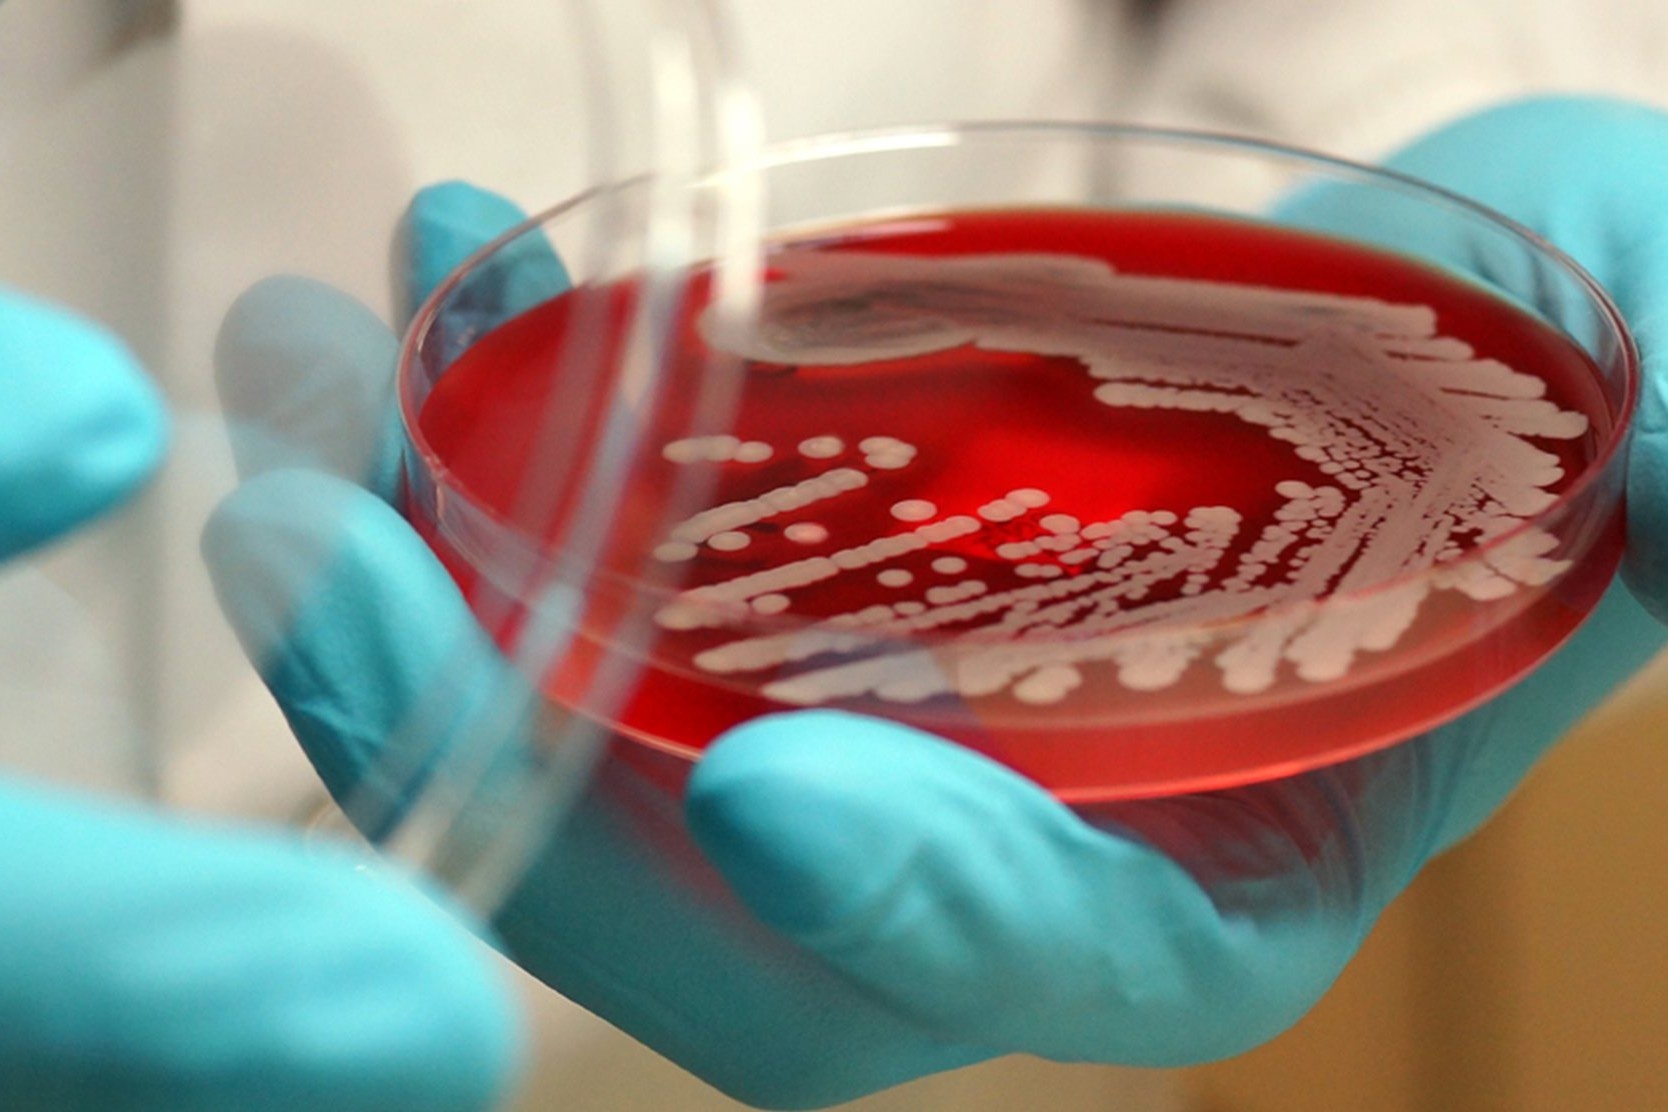

Truyền thông Thái Lan đồng loạt đưa tin ngày 27/10, Cục Quản lý Thực phẩm và Dược phẩm (FDA) nước này công bố kết quả kiểm nghiệm cho thấy một lô dầu hít thảo dược Hồng Thái công thức số 2 (số đăng ký G 309/62) không đạt tiêu chuẩn chất lượng do phát hiện nhiễm khuẩn vi sinh vượt mức cho phép.
Mẫu sản phẩm được lấy trực tiếp tại cơ sở sản xuất Hongthai Phanich Herbal Products và được phân tích bởi Cục Khoa học Y tế (Department of Medical Sciences).
Theo kết quả xét nghiệm, mẫu dầu hít bị nhiễm nhiều loại vi sinh, gồm tổng số vi khuẩn hiếu khí (Total Aerobic Microbial Count), tổng nấm men và nấm mốc (Total Combined Yeasts and Mould Count), cùng vi khuẩn thuộc chi Clostridium spp.. Những chỉ số này đều vượt ngưỡng cho phép theo tiêu chuẩn về độ tinh khiết và chất lượng trong quy định của Bộ Y tế Thái Lan ban hành năm 2021.
Vụ việc được cho là cú sốc lớn đối với ngành dược thảo Thái Lan. Phát hiện này làm dấy lên lo ngại về nguy cơ nhiễm khuẩn khi sử dụng sản phẩm không đạt chuẩn, đặc biệt trong bối cảnh dầu hít được tiêu thụ phổ biến ở mọi lứa tuổi và xuất khẩu sang nhiều quốc gia.
Vậy những loại vi sinh vượt ngưỡng cho phép có trong loại "dầu hít quốc dân" này gây hại như thế nào?
 |
| Dầu hít thảo dược Hồng Thái công thức số 2 được nhiều người sử dụng. Ảnh: MGR Online. |
Vi khuẩn hiếu khí
Vi khuẩn hiếu khí là những vi sinh vật có thể tồn tại trong môi trường có oxy, chẳng hạn như không khí bình thường, theo định nghĩa của Hiệp hội Vi sinh học Mỹ. Trong nhóm này, có các vi khuẩn hiếu khí bắt buộc như Mycobacterium tuberculosis (vi khuẩn lao) và Pseudomonas aeruginosa (trực khuẩn mủ xanh). Ngoài ra, còn có nhóm vi khuẩn tùy nghi hiếu khí, có thể sống cả khi có và không có oxy, ví dụ Staphylococcus aureus (tụ cầu vàng) và các vi khuẩn của họ Enterobacteriaceae như Escherichia coli hay Salmonella spp.
Trong dược phẩm, tổng số vi khuẩn hiếu khí (TAMC) là chỉ số phản ánh lượng vi khuẩn có thể sống và phát triển trong môi trường có oxy, được phát hiện trong mỗi mẫu kiểm nghiệm. Khi kết quả TAMC vượt quá giới hạn cho phép, điều đó cho thấy mẫu đã bị nhiễm bẩn vi sinh, có thể bắt nguồn từ quy trình sản xuất, khâu bảo quản hoặc đóng gói không đảm bảo điều kiện vệ sinh.
|
| Vi khuẩn hiếu khí khi xâm nhập vào cơ thể có thể gây nên nhiều tác động xấu. Ảnh: UCSF Health. |
Theo quy định của Bộ Y tế Thái Lan (2021) và tiêu chuẩn trong Dược điển châu Âu/USP, giới hạn tối đa của chỉ số TAMC được đặt ra nhằm đảm bảo an toàn cho người dùng. Cụ thể, dược phẩm dùng ngoài không vượt quá 1.000 CFU/g, dược phẩm dùng uống không vượt quá 100 CFU/g, và nước tinh khiết giới hạn ở mức 100 CFU/mL.
Vi khuẩn hiếu khí nhìn chung đóng vai trò quan trọng trong tự nhiên, giúp phân hủy chất hữu cơ và cân bằng hệ vi sinh. Tuy nhiên, khi xâm nhập vào cơ thể con người, đặc biệt ở người suy giảm miễn dịch, có vết thương hở hoặc đang điều trị dài ngày bằng kháng sinh, chúng có thể trở thành tác nhân gây bệnh nguy hiểm.
Một số loài như Pseudomonas aeruginosa, Staphylococcus aureus hay Acinetobacter baumannii có khả năng kháng thuốc mạnh, tạo màng sinh học giúp bám dính và né tránh hệ miễn dịch. Khi nhiễm vào đường hô hấp, máu hoặc mô sâu, các vi khuẩn này có thể gây viêm phổi, nhiễm khuẩn huyết, viêm mô hoại tử hoặc suy đa cơ quan, với tỷ lệ tử vong cao ở bệnh nhân nặng. Ngoài ra, nhiều chủng còn sản sinh độc tố, enzyme phá hủy mô và làm lan nhanh ổ nhiễm, khiến điều trị trở nên khó khăn hơn.
Nấm men, nấm mốc
Theo Trung tâm Kiểm soát và Phòng ngừa Dịch bệnh Mỹ (CDC) và Tổ chức Y tế Thế giới (WHO), nấm mốc và nấm men là hai loại vi sinh vật phổ biến trong không khí và môi trường sống, có thể trở thành mối đe dọa nghiêm trọng cho sức khỏe khi phát triển mất kiểm soát trong không gian kín.
Trong tự nhiên, chúng đóng vai trò phân hủy chất hữu cơ và duy trì cân bằng sinh thái. Nhưng khi gặp điều kiện thuận lợi như độ ẩm cao, thiếu thông gió hoặc nhiệt độ ấm, các chủng nấm này nhanh chóng phát triển, sinh ra bào tử hoặc tế bào vi nấm trôi nổi trong không khí. Khi con người hít phải hoặc tiếp xúc trực tiếp, đặc biệt ở nhóm có sức đề kháng yếu, các tác nhân này có thể gây tổn thương đường hô hấp và dẫn đến nhiều rối loạn miễn dịch.
Các nghiên cứu dịch tễ học của Viện Y học Mỹ (IOM, 2004) và WHO (2009) đã chỉ ra mối liên hệ rõ ràng giữa môi trường ẩm mốc và sự gia tăng các triệu chứng hô hấp, dị ứng, hen suyễn và viêm phổi quá mẫn.
 |
| Nấm men, nấm mốc có thể ảnh hưởng đến hệ hô hấp. Ảnh: Freepik. |
Nấm mốc như Aspergillus, Cladosporium, Penicillium thường phát tán trong không khí ẩm, gây viêm mũi dị ứng, ho, thở khò khè, đau đầu hoặc kích ứng mắt da. Với người suy giảm miễn dịch, mắc bệnh phổi mạn tính hoặc đang hóa trị, các bào tử nấm này có thể xâm nhập phổi, gây nhiễm trùng và đôi khi đe dọa tính mạng.
Trong khi đó, nấm men, đặc biệt là Candida albicans, cũng có thể trở thành tác nhân gây bệnh khi phát triển quá mức. Vốn tồn tại tự nhiên trên da, niêm mạc miệng, đường tiêu hóa và sinh dục, Candida bình thường vô hại, nhưng khi mất cân bằng vi sinh hoặc sau điều trị kháng sinh, nấm sẽ tăng sinh mạnh, dẫn đến nhiễm nấm da, miệng, âm đạo, tiêu hóa, hoặc thậm chí xâm nhập máu.
Ở bệnh nhân HIV, ung thư, ghép tạng hoặc đang dùng thuốc ức chế miễn dịch, Candida có thể gây nhiễm trùng huyết hoặc viêm phổi nặng, với tỷ lệ tử vong lên đến 30-40% theo một số nghiên cứu lâm sàng.
Vi khuẩn thuộc chi Clostridium spp
Cơ quan Y tế Công cộng Canada cho biết Clostridium spp. là nhóm vi khuẩn gram dương có khả năng sinh bào tử, thường tồn tại ở môi trường thiếu oxy. Chúng xuất hiện khắp nơi trong tự nhiên, từ đất, phân, nước thải cho tới trầm tích biển, và thậm chí có thể sống trong đường ruột của người và động vật. Dù phần lớn các loài Clostridium vô hại, một số chủng có thể sinh độc tố mạnh, gây ra nhiều bệnh lý nghiêm trọng nếu xâm nhập vào cơ thể.
Một trong những bệnh phổ biến nhất là nhiễm khuẩn huyết do Clostridium, thường biểu hiện bằng sốt, rét run và tăng bạch cầu. Tỷ lệ không qua khỏi có thể lên tới 50%. Ở mức độ nặng hơn, vi khuẩn này có thể gây hoại tử sinh hơi, tình trạng cơ bị nhiễm khuẩn nặng, sinh độc tố làm phá hủy mô, tạo bóng nước và khí dưới da. Bệnh tiến triển nhanh và có thể đe dọa tính mạng nếu không được điều trị kịp thời.
Khoảng 70% ca bệnh xảy ra sau chấn thương, chủ yếu do Clostridium perfringens. Ngoài ra, Clostridium còn liên quan đến viêm ruột hoại tử sơ sinh, một biến chứng nặng ở trẻ nhỏ, và hội chứng sốc nhiễm độc do C. sordellii, thường gặp sau sinh hoặc thủ thuật phụ khoa, với diễn tiến cực kỳ nhanh dẫn đến phù, sốc và suy đa tạng.
Vi khuẩn này không lây trực tiếp giữa người với người mà thường xâm nhập qua vết thương sâu hoặc mô bị hoại tử, cũng có thể xuất hiện trong trường hợp thủng đường tiêu hóa. Thời gian ủ bệnh dao động từ 6 giờ đến 3 ngày.
Thế nào là chế độ ăn kiêng tốt nhất? Làm thế nào để ngừng lo lắng về cân nặng và tập trung vào việc sống lành mạnh? Để giải quyết mối quan tâm về vấn đề này, mục Sức khỏe của Znews giới thiệu bạn cuốn sách Chỉ dẫn để sống khỏe toàn diện của tác giả Shaun Francis. Sách sẽ giúp người đọc tập trung việc ăn uống lành mạnh, rèn luyện thể chất và giữ tinh thần minh mẫn trong thời buổi bận rộn.


